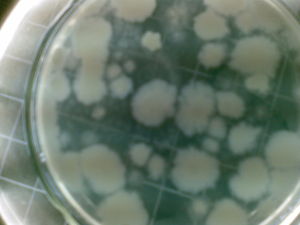
糞大腸菌群 糞大腸菌群

簡介
糞大腸菌群糞大腸菌群是大腸菌群的一種,大腸菌群並非細菌學分類命名,而是衛生細菌領域的用語,它不代表某一個或某一屬細菌,而指的是具有某些特性的一組與糞便污染有關的細菌,這些細菌在生化及血清學方面並非完全一致,其定義為:需氧及兼性厭氧、在37℃能分解乳糖產酸產氣的革蘭氏陰性無芽胞桿菌。一般認為該菌群細菌可包括大腸埃希氏菌、檸檬酸桿菌、產氣克雷白氏菌和陰溝腸桿菌等。
大腸菌群分布較廣,在溫血動物糞便和自然界廣泛存在。調查研究表明,大腸菌群細菌多存在於溫血動物糞便、人類經常活動的場所以及有糞便污染的地方,人、畜糞便對外界環境的污染是大腸菌群在自然界存在的主要原因。糞便中多以典型大腸桿菌為主,而外界環境中則以大腸菌群其他型別較多。
大腸菌群是作為糞便污染指標菌提出來的,主要是以該菌群的檢出情況來表示食品中有否糞便污染。大腸菌群數的高低,表明了糞便污染的程度,也反映了對人體健康危害性的大小。糞便是人類腸道排泄物,其中有健康人糞便,也有腸道患者或帶菌者的糞便,所以糞便內除一般正常細菌外,同時也會有一些腸道致病菌存在(如沙門氏菌、志賀氏菌等),因而食品中有糞便污染,則可以推測該食品中存在著腸道致病菌污染的可能性,潛伏著食物中毒和流行病的威脅,必須看作對人體健康具有潛在的危險性。
檢測方法
糞大腸菌為總大腸菌群的一個亞種;直接來自糞便,除了它耐熱,在44-44.5℃的高溫條件下仍可生長繁殖並將色氨酸代謝成吲哚,其他特性均與總大腸菌群相同。總大腸菌群中的細菌除生活在腸道中外,在自然環境中的水與土壤中也經常存在,但此等在自然環境中生活的大腸菌群培養的最合適溫度為25℃左右,如在37℃培養則仍可生長,但如將培養溫度再升高至44.5℃,則不再生長,而直接來自糞便的大腸菌群細菌,習慣於37℃左右生長,如將培養溫度升高至44.5℃仍可繼續生長。因此,可用提高培養溫度方法將自然環境中的大腸菌群與糞便中的大腸菌群區分。在37℃培養生長的大腸菌群,包括在糞便內生長的大腸菌群稱為“總大腸菌群”(Totalcoliform);在44.5℃仍能生長的大腸菌群,稱為“糞大腸菌群”(Fecalcoliform),糞大腸菌群細菌在衛生學上具有重要的意義。
檢驗注意事項
(1)將接種好的樣品放人恆溫水浴箱或隔水式恆溫培養箱時,箱內溫度一定要求達到所要求的溫度(44±1℃)時,方可放入。如用恆溫水浴箱其水面要高於接種物面,放濾膜的培養皿要沉到水浴箱底部。(2)MFC培養基中苯胺藍的純度和質量往往影響菌落的顏色,根據試驗結果用進口苯胺藍加O.1g,用國產苯胺藍加0.2g,培養出的糞大腸菌菌落顏色較典型。但國產苯胺藍的性能是否同樣穩定尚不能肯定。因此,制好的培養基在使用前,最好先接種典型糞大腸菌,以觀察對比菌落的顏色。
玫紅酸高壓後會分解,配好的試液應在2-lO℃保存不超過2周,如顏色由暗紅變成棕色沉澱時應棄去。如雜菌污染少,且加與不加玫紅酸對菌落計數無影響時,可不加。.
(3)在濾膜上生長的菌落除挑取藍色菌落外,淺藍色菌落或淺藍色中心較深的菌落也應挑取。
(4)生活飲用水通常都是經氯處理消毒的,水中含有一定量的余氯,使大腸菌群處於受損或受抑制狀態,在採集水樣時應加硫代硫酸鈉脫氯,使此受損的細菌得以復甦與修復,從而避免計數結果偏低甚至假陰性出現。
(5)採樣後水樣的正確保存很重要,如保存不當可使檢樣中的大腸菌群細菌死亡或在一定條件下再生長,這些都將影響檢驗結果的準確性。檢驗室接到水樣後,應立即檢驗。如因故不能檢驗時,應立即置於冰櫃內並於2小時內檢驗。